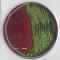

فروش محیط کشت مرک آلمان
افزودن به پسندها 📞 شماره های تماس 021-55436249
09196394325
09354536280
09196394325
09354536280
📞 اطلاعات تماس با آگهی دهنده 

اَوِسینا شیمی (1)
✔️شماره های تماس :: 021-55436249 09196394325 09354536280
توضیحات کامل آگهی
فروش انواع محیط کشت های میکروبی اَوِسینا شیمی، وارد کننده مواد مرک آلمان قیمت انواع محیط کشت میکروبی
آدرس آگهی :
K _ منطقه یازده تهران, تهران, تهران
اتوبان نواب- ساختمان سرو
اتوبان نواب- ساختمان سرو